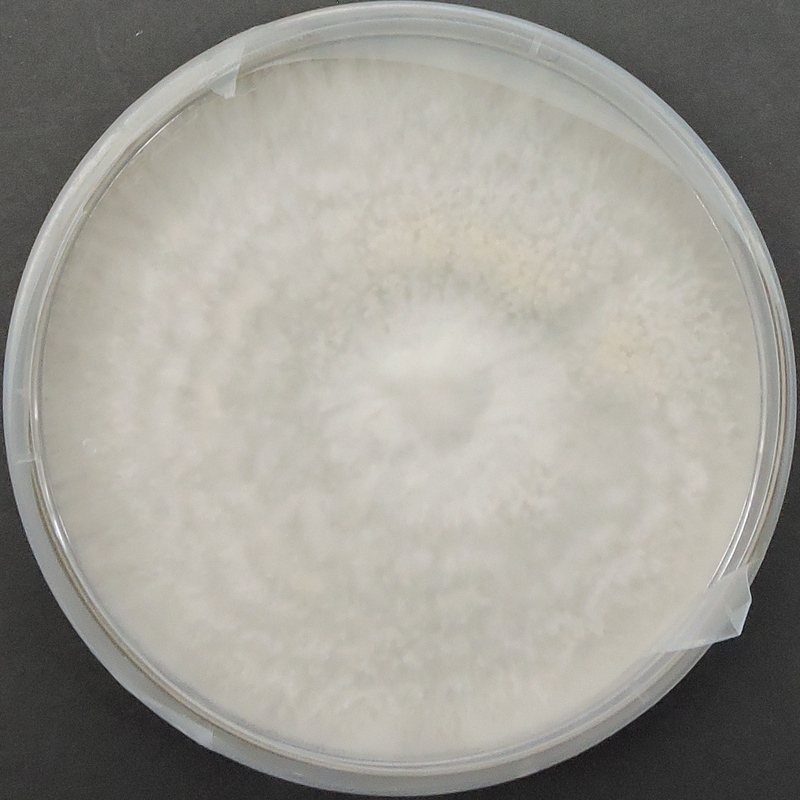

Pleurotus florida (White Oyster) – Pure Culture Plate
The White Oyster Mushroom (Pleurotus florida) is a highly productive and visually attractive oyster variety, known for its bright white caps, firm stems, and mild flavor. It thrives across a broad temperature range and adapts well to a variety of agro-based substrates, making it one of the most popular oyster strains for tropical and subtropical regions.
Our pure culture plates are prepared using aseptic techniques under sterile laboratory conditions to ensure 100% contamination-free, vigorous mycelial growth. The strain exhibits rapid colonization, consistent fruiting, and high biological efficiency—making it ideal for both commercial growers and educational labs.
Ideal for:
Spawn laboratories and commercial mushroom producers
Home growers and mushroom enthusiasts
Training and demonstration purposes
Key Features:
Bright white fruiting bodies with uniform size and shape
Excellent yield and short cropping cycle
Strong adaptability to straw, sawdust, and agri-waste substrates
Suitable for warm and moderate climates (20–30°C)
Mild, pleasant flavor with great culinary value
Storage & Handling:
Store under refrigeration (2–8°C). Use within 3–4 weeks of purchase for best culture vitality.
🍄 Proudly prepared and stored at Agripie Agrosystem LLP, India 🇮🇳

 |
|  |
| 
